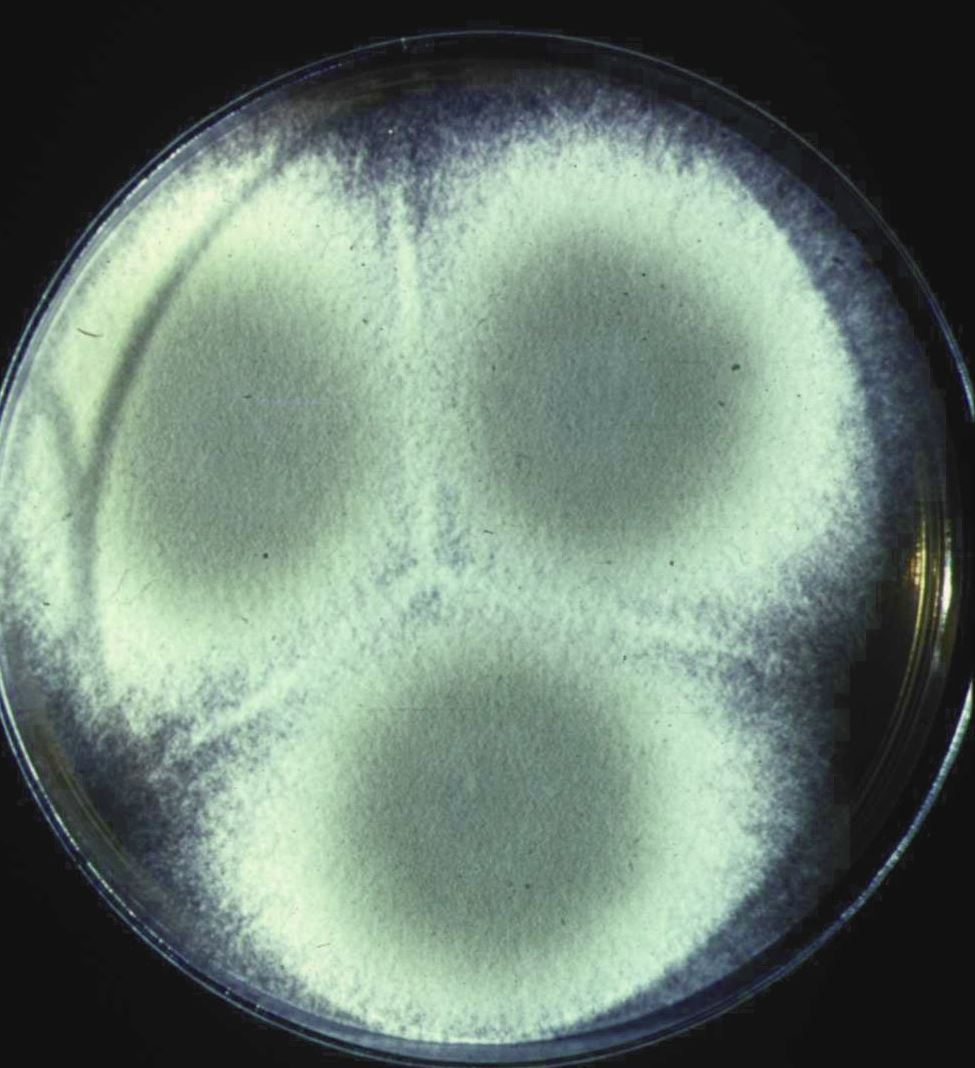
Penicillium digitatum in ambiente domestico

Penicillium digitatum: identificazione, rischi e interventi in ambito domestico
Il Penicillium digitatum è una delle muffe più aggressive che possono colonizzare gli ambienti domestici, particolarmente temuto per la sua resistenza ai comuni trattamenti antifungini e per la produzione di micotossine pericolose per la salute. Se hai notato macchie verdastre persistenti nelle tue stanze, accompagnate da odori sgradevoli che non spariscono nonostante le pulizie, potresti trovarti di fronte a questa specie fungina. Comprensibilmente, la preoccupazione per la salute della tua famiglia è legittima: questa muffa può causare problemi respiratori e, in soggetti sensibili, reazioni allergiche significative. La buona notizia è che, con le giuste conoscenze e un approccio metodico, è possibile identificare correttamente il problema e risolverlo definitivamente, ripristinando un ambiente domestico salubre e sicuro per tutti.
Cos'è il Penicillium digitatum e come si sviluppa
Il Penicillium digitatum è una specie fungina appartenente alla famiglia delle muffe filamentose, caratterizzata da una particolare aggressività e capacità di adattamento agli ambienti domestici. Questa muffa si distingue visivamente per le sue spore di colore giallo-verdastro o olivastro, circondate tipicamente da un piccolo cerchio di micelio bianco che rappresenta la struttura vegetativa del fungo.
Dal punto di vista delle condizioni ambientali preferite, il Penicillium digitatum dimostra una notevole versatilità termica, crescendo in un intervallo che va dai 6-7°C fino a un massimo di 37°C. La sua crescita ottimale si registra attorno ai 24°C, una temperatura molto comune nelle nostre abitazioni, soprattutto durante i mesi autunnali e invernali quando il riscaldamento domestico crea le condizioni ideali.
Un altro fattore critico per il suo sviluppo è il pH del substrato, che deve essere compreso tra 5,5 e 7 - valori tipici di molti materiali edili come intonaci, carte da parati e materiali organici presenti in casa. Il fungo si riproduce asessualmente tramite spore, un meccanismo che gli consente di diffondersi rapidamente attraverso l'aria e colonizzare nuove superfici con estrema efficienza.
Secondo i dati dell'Istituto Superiore di Sanità, le specie di Penicillium rappresentano circa il 15-20% delle contaminazioni fungine rilevate negli ambienti indoor italiani, con il Penicillium digitatum che costituisce una frazione significativa di questo gruppo.
Rischi per la salute e aspetti normativi
La pericolosità del Penicillium digitatum per la salute umana si manifesta attraverso diversi meccanismi, che è importante conoscere per una corretta valutazione del rischio nella propria abitazione.
I soggetti più vulnerabili sono principalmente:
- Persone con sistema immunitario compromesso (anziani, bambini, pazienti oncologici)
- Individui affetti da patologie respiratorie croniche come asma o broncopneumopatia cronica ostruttiva
- Soggetti con allergie preesistenti o predisposizione atopica
Le principali manifestazioni cliniche dell'esposizione possono includere:
- Reazioni allergiche respiratorie, che vanno dalla rinite alla polmonite
- Crisi asmatiche in soggetti predisposti
- Irritazioni delle mucose oculari e nasali
- In casi estremi, infezioni sistemiche (documentato un solo caso di polmonite fatale in letteratura scientifica)
Aspetto rassicurante: È importante sottolineare che nel siero umano degli individui sani è generalmente presente una concentrazione di anticorpi naturali diretti contro il polisaccaride extracellulare del Penicillium digitatum, fornendo una protezione naturale di base.
Un aspetto particolarmente preoccupante è la produzione di micotossine, sostanze tossiche che questa muffa rilascia nell'ambiente. La principale è la citrinina, una micotossina che presenta:
- Effetti nefrotossici: danneggia i vasi sanguigni e compromette il flusso sanguigno ai reni
- Proprietà embriotossiche: può interferire con lo sviluppo embrionale
- Potenziale cancerogeno per uomo e animali, secondo le classificazioni internazionali
Dal punto di vista normativo, in Italia non esistono limiti specifici per le concentrazioni di Penicillium digitatum negli ambienti indoor, ma si fa riferimento alle Linee Guida dell'Istituto Superiore di Sanità che raccomandano concentrazioni inferiori a 50 UFC/m³ (Unità Formanti Colonie per metro cubo) per la somma di tutte le specie fungine presenti.
Come si misura e come intervenire
L'identificazione corretta del Penicillium digitatum nella tua abitazione richiede un approccio metodico che combina osservazione visiva e analisi specialistiche.
Segnali visivi da riconoscere:
- Macchie di colore giallo-verdastro o olivastro
- Presenza di un alone bianco attorno alle zone colorate
- Crescita preferenziale su superfici leggermente umide
- Odore caratteristico dolciastro-terroso
Per una diagnosi definitiva, è necessario effettuare:
- Campionamento dell'aria mediante aspiratori specifici (sistema SAS - Surface Air System)
- Prelievi su superficie con tamponi sterili
- Analisi microscopiche per l'identificazione morfologica
- Test di sensibilità agli antifungini per pianificare l'intervento
La resistenza agli antifungini rappresenta una delle maggiori sfide nella gestione del Penicillium digitatum. Molti biocidi chimici comuni risultano inefficaci, e spesso sono necessari trattamenti specifici con formaldeide o pirimetanil, da utilizzare esclusivamente sotto supervisione specialistica.
Sensibilità agli antifungini e approccio terapeutico

Il concetto di MIC (concentrazione minima inibente) rappresenta la concentrazione più bassa di un antimicotico in grado di bloccare la crescita del fungo, espressa in μg/mL. Parallelamente, la MEC (Minimum Effective Concentration) indica la concentrazione minima efficace per un controllo duraturo.
Principali antifungini valutati:
- AmB = Amfotericina B liposomiale
- VORI = Voriconazolo
- POSA = Posaconazolo
- ITRA = Itraconazolo
- ISAV = Isavuconazolo
- FLU = Fluconazolo
- ANID = Anidulafungina
- CAS = Caspofungina
- MICA = Micafungina
- 5FC = 5-Fluorocitosina
- TERB = Terbinafina
Importante: I dati di sensibilità riportati sono esclusivamente orientativi. Ogni intervento richiede test specifici per il ceppo identificato nella tua abitazione. È sconsigliato l'uso autonomo di questi prodotti senza supervisione specialistica.
Strategia di intervento consigliata:
- Indagine microbiologica preliminare per identificazione e tipizzazione
- Test di sensibilità antifungina specifici
- Sanificazione mirata con prodotti efficaci sul ceppo identificato
- Rimozione e ripristino dei materiali compromessi
- Monitoraggio post-intervento per verificare l'efficacia
Per approfondire come viene effettuata la come si diagnostica la patologia edile e quali soluzioni vengono indicate nella relazione tecnica, consulta la pagina dedicata.
Hai trovato Penicillium digitatum nella tua casa?

Temi che in casa tua possano esserci muffe pericolose per la salute? L'unico modo per scoprirlo è un'indagine microbiologica: un tecnico viene direttamente a casa tua, preleva campioni dalle pareti e dall'aria, e dopo l'analisi in laboratorio ricevi una relazione tecnica con l'identificazione certa delle specie fungine e il livello di contaminazione del tuo ambiente domestico. Il servizio è eseguito con il supporto di laboratorio specializzato.
Indagine microbiologica specialistica: 500 €, tasse comprese.
Se necessario, possiamo anche effettuare test di efficacia dei sanificanti sul tipo di muffa individuato, per garantire che l'intervento di bonifica sia mirato ed efficace.
Prezzi riferiti ad appartamenti fino a 100 m², escluse eventuali spese di trasferta.
📍 Servizio attivo nelle province di Salerno e Avellino.
Domande frequenti
Il Penicillium digitatum è più pericoloso di altre muffe comuni?
Sì, presenta una pericolosità superiore alla media per due motivi principali: la produzione della micotossina citrinina e l'elevata resistenza ai comuni antifungini. Tuttavia, con un intervento tempestivo e mirato, il problema è completamente risolvibile senza rischi permanenti per la salute.
Posso riconoscere questa muffa dal colore o dall'odore?
Il Penicillium digitatum si presenta tipicamente con colorazione giallo-verdasta o olivastra, circondata da un alone bianco. L'odore è dolciastro-terroso, ma per una identificazione certa è sempre necessaria l'analisi microscopica specialistica.
I prodotti antimuffa del supermercato sono efficaci?
Purtroppo no. Questa specie presenta una resistenza molto elevata ai comuni biocidi commerciali. Sono necessari trattamenti specifici con formaldeide o pirimetanil, utilizzabili solo da personale specializzato con adeguate protezioni.
Quanto tempo serve per eliminare completamente l'infestazione?
I tempi variano da 2-3 settimane per interventi localizzati fino a 1-2 mesi per infestazioni estese. Include le fasi di sanificazione, asciugatura, ripristino materiali e monitoraggio finale. La tempestività dell'intervento influenza significativamente i tempi di risoluzione.
Dopo la rimozione, può ripresentarsi il problema?
Se vengono eliminate correttamente sia la muffa che le cause di umidità sottostanti, la ricomparsa è molto improbabile. È fondamentale però intervenire anche sui fattori predisponenti come infiltrazioni, ponti termici o scarsa ventilazione per garantire risultati duraturi.
Il Penicillium digitatum rappresenta una sfida impegnativa ma non insormontabile per la salute dell'ambiente domestico. La chiave del successo risiede nell'approccio metodico: identificazione corretta, analisi delle cause scatenanti e intervento specialistico mirato. Con le competenze appropriate e gli strumenti adeguati, è possibile ripristinare completamente la salubrità della tua abitazione, garantendo un ambiente sicuro per tutta la famiglia.
Il presente servizio è attivo esclusivamente nei seguenti comuni: Salerno, Cava de' Tirreni, Castiglione del Genovesi, Pellezzano, Vietri sul Mare, Baronissi, Fisciano, Pontecagnano Faiano, San Mango Piemonte, Cetara, Bellizzi, Nocera Inferiore, Mercato San Severino, Pagani, Battipaglia, Sant'Egidio del Monte Albino, Montoro Inferiore, Minori, Maiori, Corbara, Nocera Superiore, Eboli, Roccapiemonte, Angri, Atrani, Montecorvino Pugliano, Castel San Giorgio, Amalfi, San Valentino Torio, Solofra, San Marzano sul Sarno, Sarno, Bracigliano, Scafati, Pompei, Montoro Superiore, Siano, Sant'Antonio Abate, Santa Maria la Carità, Striano, Forino, Ravello, Gragnano, Poggiomarino, Torre Annunziata, San Cipriano Picentino, Scala, Lettere, Casola di Napoli, Praiano, Conca dei Marini, Tramonti, Serino, Castellammare di Stabia, San Giuseppe Vesuviano, Santo Stefano del Sole, Cesinali, Terzigno, Campagna, Palma Campania, Ottaviano, Aiello del Sabato, Trecase, Albanella, San Gennaro Vesuviano, Calvanico, Atripalda, Capriglia Irpina, Pimonte, Marigliano, Nola, San Paolo Bel Sito, Contursi Terme, Furore, Torre del Greco, Mariglianella, Avellino, Contrada, Vico Equense, Tufino, San Vitaliano, Scisciano, Comiziano, Saviano, Casamarciano, Camposano, San Sebastiano al Vesuvio, Somma Vesuviana, Brusciano, Palomonte, Portici, Cicciano, Acerno, Cercola, San Giorgio a Cremano, Sant'Anastasia, Pomigliano d'Arco, Oliveto Citra, Domicella, Colliano, Baiano, Montefalcione, Pratola Serra, Volla, Altavilla Silentina, Sicignano degli Alburni, Liveri, Castello di Cisterna, Polla, Agerola, Pollena Trocchia, Napoli, Cimitile, Avella, Acerra, Montefredane, San Michele di Serino, Monteforte Irpino, Mercogliano, Positano, Candida, Parolise, Lauro, Moschiano, Manocalzati, Olevano sul Tusciano, Quindici, Giffoni Valle Piana, Valva, Buccino, Giffoni Sei Casali, Visciano, Carbonara di Nola, Postiglione, Casavatore, Pertosa, Casoria, Sorbo Serpico, San Potito Ultra, Pago del Vallo di Lauro, Casalnuovo di Napoli, Romagnano al Monte, Auletta, Recale, Casagiove, San Nicola la Strada, Sant'Angelo a Scala, Marzano di Nola, Mugnano del Cardinale, Afragola, Arzano, Crispano, Casapulla, Meta, Grottolella, Ospedaletto d'Alpinolo, Taurano, Pietradefusi, Montemiletto, Capaccio, Castelcivita, Santomenna, Curti, San Prisco, Sirignano, Petina, Caserta, Capodrise, Trentinara, Torre Le Nocelle, Caivano, Cardito, Melito di Napoli, Sant'Arpino, Succivo, Sala Consilina, San Felice a Cancello, Santa Maria a Vico, Portico di Caserta, Piano di Sorrento, Montefusco, Roccarainola, Frattaminore, Frattamaggiore, Grumo Nevano, Cesa, Macerata Campania, Santa Maria Capua Vetere, San Rufo, Quadrelle, Aquara, Marcianise.